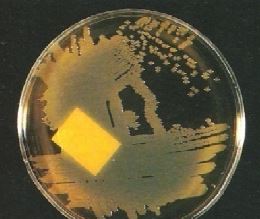

النبات

مواضيع عامة في علم النبات

الجذور - السيقان - الأوراق

النباتات الوعائية واللاوعائية

البذور (مغطاة البذور - عاريات البذور)

الطحالب

النباتات الطبية


الحيوان

مواضيع عامة في علم الحيوان

علم التشريح

التنوع الإحيائي

البايلوجيا الخلوية


الأحياء المجهرية

البكتيريا

الفطريات

الطفيليات

الفايروسات


علم الأمراض

الاورام

الامراض الوراثية

الامراض المناعية

الامراض المدارية

اضطرابات الدورة الدموية

مواضيع عامة في علم الامراض

الحشرات


التقانة الإحيائية

مواضيع عامة في التقانة الإحيائية


التقنية الحيوية المكروبية

التقنية الحيوية والميكروبات

الفعاليات الحيوية

وراثة الاحياء المجهرية

تصنيف الاحياء المجهرية

الاحياء المجهرية في الطبيعة

أيض الاجهاد

التقنية الحيوية والبيئة

التقنية الحيوية والطب

التقنية الحيوية والزراعة

التقنية الحيوية والصناعة

التقنية الحيوية والطاقة

البحار والطحالب الصغيرة

عزل البروتين

هندسة الجينات


التقنية الحياتية النانوية

مفاهيم التقنية الحيوية النانوية

التراكيب النانوية والمجاهر المستخدمة في رؤيتها

تصنيع وتخليق المواد النانوية

تطبيقات التقنية النانوية والحيوية النانوية

الرقائق والمتحسسات الحيوية

المصفوفات المجهرية وحاسوب الدنا

اللقاحات

البيئة والتلوث


علم الأجنة

اعضاء التكاثر وتشكل الاعراس

الاخصاب

التشطر

العصيبة وتشكل الجسيدات

تشكل اللواحق الجنينية

تكون المعيدة وظهور الطبقات الجنينية

مقدمة لعلم الاجنة


الأحياء الجزيئي

مواضيع عامة في الاحياء الجزيئي


علم وظائف الأعضاء


الغدد

مواضيع عامة في الغدد

الغدد الصم و هرموناتها

الجسم تحت السريري

الغدة النخامية

الغدة الكظرية

الغدة التناسلية

الغدة الدرقية والجار الدرقية

الغدة البنكرياسية

الغدة الصنوبرية

مواضيع عامة في علم وظائف الاعضاء

الخلية الحيوانية

الجهاز العصبي

أعضاء الحس

الجهاز العضلي

السوائل الجسمية

الجهاز الدوري والليمف

الجهاز التنفسي

الجهاز الهضمي

الجهاز البولي


المضادات الميكروبية

مواضيع عامة في المضادات الميكروبية

مضادات البكتيريا

مضادات الفطريات

مضادات الطفيليات

مضادات الفايروسات

علم الخلية

الوراثة

الأحياء العامة

المناعة

التحليلات المرضية

الكيمياء الحيوية

مواضيع متنوعة أخرى

الانزيمات
الحالات المرضية البكتيرية : الحالة الثالثة والعشرون
المؤلف:
عبد الرزاق سليمان التومي ، محمد محمد الامام ، عبد الباسط رمضان
المصدر:
اساسيات التشخيص البكتريولوجي المعملي والسريري
الجزء والصفحة:
1-9-2016
1657
الحالات المرضية البكتيرية : الحالة الثالثة والعشرون
مهندس مدني كان في رحلة سفر للهند ، بعد عودته مباشرة أصيب بإسهال مائي حاد وبعد 24 ساعة أصيب بالتجفاف نتيجة للإسهال . تم زراعة عينة البراز على الوسط الغذائي Thiosulphate citrate bile salt agar (TCBS) فأظهرت النمو كما في الشكل رقم 1 .
شكل رقم 1.23 المزرعة البكتيرية
الأسئلة :
1- ما تشخيصك المتوقع لهذه الحالة ؟ وكيف يمكنك التأكد من هذا التشخيص ؟
2- ما هي ميكانيكية إحداث المرض؟
3- ما هي الاحتياطات الصحية الواجب اتخاذها؟
الإجابة :
1- التشخيص المتوقع لهذه الحالة هي إصابة المريض بمرض الكوليرا "الهيضة" (Cholera)..
التجفاف السريع الذي أصيب به المريض سببه فقدان كمية كبيرة جداً من السوائل والإلكترولايتات (electrolytes) كنتيجة للإسهال ويكون لون البراز شيبه بماء الأرز، ويتم زراعة العينة في الوسط الغذائي التفريقي (TCBS) حيث تتكون مستعمرات صفراء اللون تدل على وجود النوع البكتيري Vibrio cholerae ويتم التأكد من هذا التعريف بإجراء الاختبارات الكيموحيوية وكذلك الاختبارات المصلية . يوجد عدة أنواع مختلفة من الجنس البكتيري Vibrio وهي تتواجد بصورة طبيعية في مياه البحار والأنهار بحيث تسبب إصابات سطحية للجلد نتيجة الاستحمام بمياه ملوثة بهذه البكتيريا، وقد تحدث إصابات معد ـت معوية نتيجة تناول الأصداف الملوثة بالنوع البكتيري V. paraheamolyticus اما النوع البكتيري V. cholerae فهي تسبب مرض الكوليرا.
2- يتكون ذيفان الجنس البكتيري Vibrio Spp من عدة مركبات بروتينية بها 5 وحيدات تساهم في التحام الذيفان بالمستقبل المتواجد على الخلايا المعد ـت معوية وتساهم في دخول الجزء الفعال لهذا الذيفان ليصل إلى سيتوبلازم الخلية حيث يؤثر على البروتين المنظم لإنزيم adeny1 cyclase والذي يتواجد في غشاء الخلايا الظهارية المعد ـت معوي مما يؤدي لزيادة معدل الـ (CAMP) في الخلية فينتج عنه فقدان كميات كبيرة من السوائل والإلكترولايتات من القناة الهضمية تحديداً الأمعاء.
3- ينتشر مرض الكوليرا نتيجة عدم الاهتمام بتصريف مياه الصرف الصحي، في حالة هذا المريض فإنه يجب ان يتم عزله مع إعطائه سوائل لمنع حدوث التجفاف مع إعطائه المضاد الحيوي tetracycline مع ضرورة إبلاغ السلطات المختصة في الأمراض السارية.
من الممكن إعطاء تطعيم للأشخاص المسافرين إلى المناطق الموبوءة بمرض الكوليرا مع أن الوقاية لا تستمر لفترات طويلة وغير فعالة بصورة كافية (حوالي 50%).
 الاكثر قراءة في البكتيريا
الاكثر قراءة في البكتيريا
 اخر الاخبار
اخر الاخبار
اخبار العتبة العباسية المقدسة

الآخبار الصحية















 قسم الشؤون الفكرية يصدر كتاباً يوثق تاريخ السدانة في العتبة العباسية المقدسة
قسم الشؤون الفكرية يصدر كتاباً يوثق تاريخ السدانة في العتبة العباسية المقدسة "المهمة".. إصدار قصصي يوثّق القصص الفائزة في مسابقة فتوى الدفاع المقدسة للقصة القصيرة
"المهمة".. إصدار قصصي يوثّق القصص الفائزة في مسابقة فتوى الدفاع المقدسة للقصة القصيرة (نوافذ).. إصدار أدبي يوثق القصص الفائزة في مسابقة الإمام العسكري (عليه السلام)
(نوافذ).. إصدار أدبي يوثق القصص الفائزة في مسابقة الإمام العسكري (عليه السلام)


















